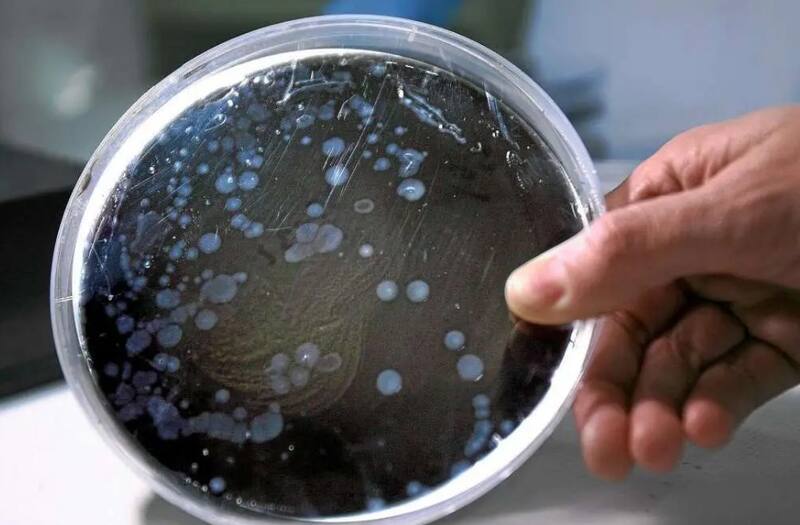

En esta noticia
Hace unos días se confirmó un caso positivo de Legionella en La Plata. Se trata de un hombre, de 49 años, que continúa internado en la Unidad de Cuidados Intensivos del Hospital San Martín.
Según detallaron medios locales, el paciente llegó con un diagnóstico de Mieloma Múltiple y fue derivado, de urgencia, a la Unidad de Trasplante.
La Organización Mundial de la Salud (OMS) establece que la enfermedad presenta diferentes cuadros de gravedad. Estos incluyen desde afecciones leves, como fiebre, hasta neumonías mortales.

Qué es la Legionella
El Instituto Malbrán explicó que la legionelosis es una forma de neumonía, potencialmente moral, que se contrae a través de la inhalación de aerosoles o gotas de agua contaminas con la bacteria Legionella.
Estas partículas se encuentran en ambientes de agua dulce como lagos y/o arroyos. Sin embargo, pueden convertirse en una preocupación cuando se propagan más allá de su hábitat.
Cuáles son los síntomas de la Legionella
Los signos más comunes son:
- Tos.
- Dificultad para respirar.
- Fiebre.
- Dolores musculares.
- Dolores de cabeza.
- Diarrea.
- Náuseas.
- Confusión.
En la mayoría de los casos, los primeros síntomas aparecen entre 2 y 14 días después de la exposición.

Legionella: ¿cómo se contagia?
Según los Centros para el Control y Prevención de Enfermedades (CDC), después de que las bacterias crecen y se multiplican en el sistema pluvial de un edificio, "el agua que las contiene puede dispersarse en forma de gotitas suficientemente pequeñas como para que las personas las inhalen".
Cómo es el tratamiento contra la Legionella
Según los CDC, el tratamiento está basado en antibióticos. De esta manera, la mayoría de los casos son tratados de forma eficaz. Sin embargo, con frecuencia, algunos pacientes necesitan ser atendido en un hospital.
Las posibles complicaciones son:
- Insuficiencia pulmonar.
- Muerte.
Legionella: ¿cuál es la tasa de mortalidad?
La tasa de mortalidad por legionelosis dependerá de:
- La gravedad de la enfermedad.
- Idoneidad del tratamiento inicial.
- Características del huésped.
- Lugar de contagio.
En personas inmunodeprimidas el riesgo puede alcanzar hasta el 80%. Sin embargo, se reduce a un 5%-30% en personas que no presentan patologías prexistentes.













